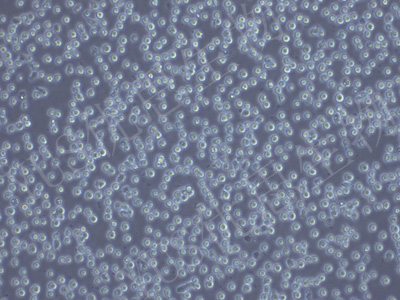

产品中心
产品中心
-

C127 小鼠乳腺肿瘤细胞(种属鉴定)
货号:YLM141规格: 1*10^6 -

P3X63Ag8 小鼠骨髓瘤细胞(种属鉴定)
货号:YLM142规格: 1*10^6 -
L6565 小鼠白血病克隆细胞系)(STR鉴定)
货号:YLM143规格: 1*10^6 -

P3/NSI/1-Ag4-1 小鼠骨髓瘤细胞(STR鉴定)
货号:YLM144规格: 1*10^6 -

AE-1 小鼠杂交瘤细胞(抗AChE)(STR鉴定)
货号:YLM145规格: 1*10^6 -

AE-2 小鼠杂交瘤细胞(抗AChE)(STR鉴定)
货号:YLM146规格: 1*10^6 -

35.1 杂交瘤细胞抗(CD2)(STR鉴定)
货号:YLM147规格: 1*10^6 -

PK136 小鼠×小鼠杂交瘤细胞(IgG2a)(STR鉴定)
货号:YLM148规格: 1*10^6
在线咨询
Online consultation

关注微信公众号


